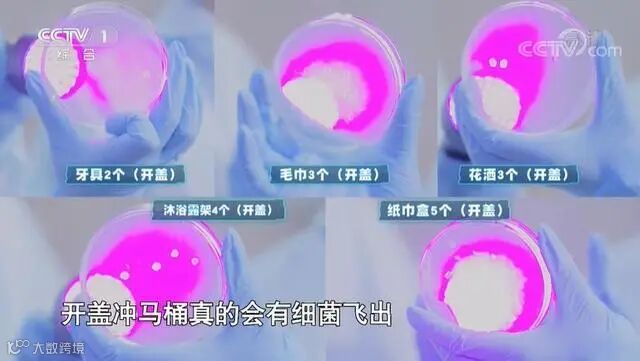

01
家有阳性患者
要注意些什么?要消毒吗?
① 避免接触
其他同住人员应尽量避免与阳性患者接触,禁止共用生活用品,及时对阳性患者使用或者接触过的物品及其表面进行消毒。
接触或者处理阳性患者的污染物时,应当做好自我防护,佩戴N95口罩、一次性手套,交流时保持1米以上距离,及时进行手部清洁消毒。
②开窗通风
各居室应关闭房门独立开窗通风,房间每日至少上、下午各进行1次开窗通风,每次30分钟以上。
不具备自然通风条件的,可用排气扇进行机械通风。中央空调暂停使用。

③清洁消毒
居家应当以清洁卫生与随时消毒相结合,每日至少进行1次房间湿式清扫。
消毒并非必须使用化学消毒剂,也可选用阳光暴晒、热力(煮沸等)物理消毒方法。应对重点环节、场所和对象进行消毒,如收取快递、卫生间、餐饮具、以及水龙头、门把手、电源开关等高频接触物品表面。

图源:小红书@煮子vlog
02
阳性患者居家时
不同环境和物品,该如何消毒?
要在做好室内日常清洁、开窗通风的同时,进行消毒。
①地面
首先做好清洁工作,用有效氯浓度为500mg/L的含氯消毒剂(如含氯消毒剂泡腾片、84消毒液等)进行喷洒或拖拭消毒,消毒作用30-60分钟后再用清水拖地1-2遍。
②物体表面
家中台面、门把手、开关、水龙头等日常可能频繁接触到的物品表面,每日可用消毒湿巾或者蘸湿消毒液的抹布进行至少1次的擦拭消毒。
③餐饮具
完全浸泡在水中,水沸腾后开始计时,煮沸30分钟。也可以将餐具放入符合国家标准要求的餐具消毒柜,依据产品说明书进行消毒操作。

④小件用品
电子产品、个人小件用品等可以使用消毒湿巾或75%酒精擦拭消毒。
⑤衣物
衣服、被褥需经常清洗、晾晒。如确需预防性消毒时,毛巾、衣物等纺织品可煮沸消毒30分钟或用消毒剂浸泡(浓度和时间参照说明书)。有消毒功能的洗衣机,按照使用要求选择使用。
注意:含氯消毒剂对有色织物有漂白作用,消毒衣物请慎用。
⑥下水道
家里的下水道口,记得每天注水2次以上,每次不少于350毫升,或者用一个塑料袋灌水扎紧,放在地漏上以达到阻隔气溶胶反冲所带来的感染风险。
⑦快递和外卖
收取快递、外卖时,做到无接触配送,用消毒液擦拭或喷洒快递外包装,作用一定时间后,拆除外包装并及时丢弃,同时应做好手卫生。

03
家里只有一个卫生间
如何进行消毒?
当家中有阳性患者时,卫生间是居家消毒的重点区域,特别是一家人共用卫生间的,要格外注意。
阳性患者使用卫生间时,其他家庭成员要先回到自己的房间,等阳性患者用完卫生间、对卫生间进行消毒后,其他人员再使用。
阳性患者用完卫生间后,在保持房门关闭的情况下,将马桶盖翻下来再冲水,同时,还要将卫生间的窗户打开,有助于空气流通。
如果阳性患者身体状况较好,用完卫生间后,尽量自己用含氯消毒剂或消毒湿巾对卫生间区域进行喷洒消毒或擦拭消毒,像水龙头、门把手等地方可以进行擦拭消毒。
如果阳性患者身体状况不太好,其他家庭成员对卫生间进行消毒时,要做好防护,戴好口罩、一次性手套等,避免感染。
图片来源:央视新闻
04
阳性患者的生活垃圾
需要如何处理?
阳性患者用过的纸巾、口罩、一次性手套、隔离期间吃剩的饭菜,以及抗原检测使用完后的废弃物,都应装入塑料袋,放置到专用垃圾桶。
清理前用有效氯为1000mg/L的含氯消毒剂或75%酒精喷洒消毒至完全湿润,然后扎紧塑料口袋,按照当地社区要求进行指定地点投放,同时,规范佩戴口罩并做好手卫生。

05
“阳过”后
该怎么给居室环境进行消毒?
病毒在室温下是不能长时间存活的。因此,康复后的家庭不需要特殊消毒,只需对一些重点部位进行消毒。
①冰箱
家庭里的冰箱冷藏室4-5℃,冷冻室-18℃,温度较低,病毒存活时间较长。
“阳过”康复后,可拔掉冰箱电源,恢复常温后,用75%酒精或消毒湿巾把冰箱以及食品外包装擦拭一遍,冰箱内的食物加热后再食用,可消除病毒感染的风险。
②马桶
家庭里马桶、洗手池可能残存感染者患病期间的呼吸道分泌物,“阳过”康复后可用75%酒精或含氯消毒液或消毒湿巾擦拭进行消毒。
③桌面、柜子等硬质表面
病毒在硬质物表的存活时间有限,用75%酒精或含氯消毒液或消毒湿巾擦拭就可以了。

06
“阳康”后
以前的衣服还能穿吗?
感染期间的衣物和生活用品上可能有病毒残留,但病毒在体外存活时间不会太长,适当处理的话不会有传染风险。
建议将感染期间的衣物和生活用品打包封存一周左右,再按常规清洗或清洁。对耐湿耐热衣物、被服等也可以高温清洗或使用专门衣物消毒液浸泡消毒。

07
如何选择消毒剂?
①手消毒
可选手卫生专用消毒剂(醇类或季铵盐类);
②环境物品表面消毒
如门把手、扶手等,可选用消毒湿巾擦拭,或选择含氯消毒剂、季铵盐类消毒剂等。不建议用酒精进行大面积喷洒消毒,防止酒精在空气中见火爆燃;
③手机、钥匙等小物件
可用75%酒精擦拭表面消毒。

08
不同类型的消毒剂
可以混合使用吗?
不可以。
如84消毒液与洁厕剂混合,会产生有毒气体,刺激人体咽喉、呼吸道和肺部而引发中毒。洗衣液同样不宜与消毒剂混合使用。




